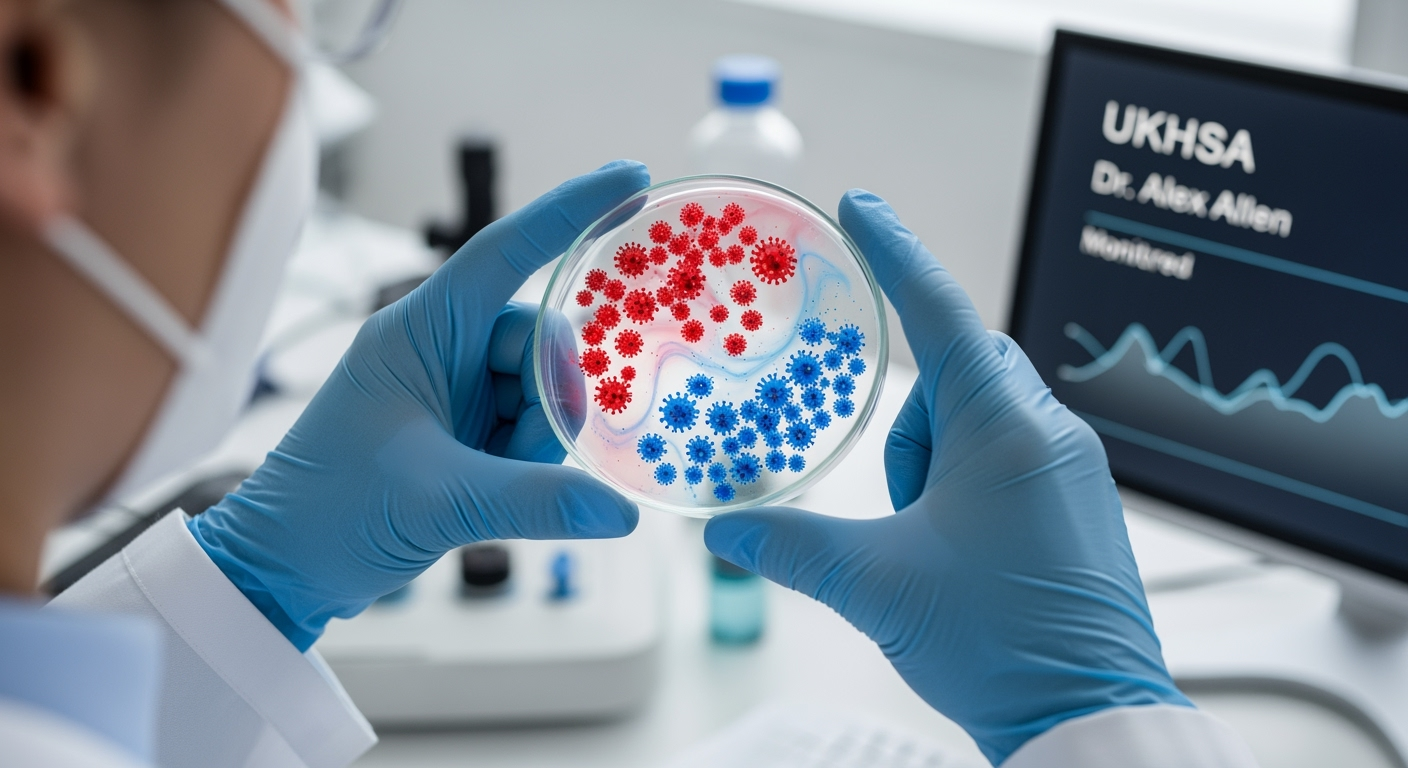
Une augmentation des cas, mais pas de panique chez les experts

Nouveau variant Covid XFG.3 : les symptômes de la souche ‘Stratus’ qui se propage dans le monde
Auteur: Simon Kabbaj
On pensait peut-être en avoir fini avec lui, mais le virus du Covid-19 continue d’évoluer. Plus de cinq ans après le début de la pandémie, une nouvelle souche, surnommée ‘Stratus’, a fait son apparition et se propage, notamment en Grande-Bretagne. Ce nouveau variant, avec ses sous-lignages XFG et XFG.3, est responsable d’une part importante des nouveaux cas. Alors, faut-il s’inquiéter ? Et quels sont les symptômes à surveiller ? Faisons le point.
Une augmentation des cas, mais pas de panique chez les experts
Les chiffres montrent une augmentation des cas de Covid en Angleterre, avec une hausse de 7,6 % début septembre. Mais malgré cette propagation, les experts de l’agence de sécurité sanitaire britannique (UKHSA) se veulent rassurants. Le Dr Alex Allen, épidémiologiste, a rappelé qu’il était ‘normal que les virus mutent et changent avec le temps‘. Toutes les souches sont surveillées en permanence, et pour l’instant, rien d’alarmant n’a été détecté.
Selon la source : UKHSA
Les symptômes de 'Stratus' : un signe particulier à surveiller

La plupart des symptômes du variant ‘Stratus’ sont les mêmes que ceux que nous connaissons déjà : fièvre, toux, fatigue, maux de tête, etc. Cependant, les experts ont remarqué qu’un symptôme semblait particulièrement fréquent avec cette nouvelle souche : la voix enrouée. Si vous avez soudainement la voix d’un fumeur de gitanes sans raison, cela pourrait donc être un signe du nouveau Covid.
Pas plus dangereux et les vaccins toujours efficaces

C’est la nouvelle la plus rassurante. Pour l’instant, les experts n’ont constaté aucune augmentation de la gravité des symptômes. ‘Stratus’ ne semble donc pas plus dangereux que les souches précédentes. De plus, les vaccins actuels contre le Covid-19 seraient toujours aussi efficaces pour nous protéger contre les formes graves de la maladie. ‘Il n’y a aucune preuve suggérant que les vaccins en usage actuel seront moins efficaces’, a expliqué le Dr Allen.
Que faire si on est positif ? Les recommandations ne changent pas

Si vous avez des symptômes et que vous êtes positif au Covid, que ce soit cette nouvelle souche ou une autre, les consignes restent les mêmes. Il n’y a plus de restrictions obligatoires, mais le bon sens prévaut. Il est recommandé de rester à la maison si possible, et surtout d’éviter tout contact avec les personnes fragiles (personnes âgées, immunodéprimées…) pour ne pas leur transmettre le virus.
Et pour les enfants ?

Pour les enfants, les consignes sont également les mêmes. Il n’est pas interdit d’envoyer un enfant positif à l’école, mais il est recommandé de le garder à la maison s’il ne se sent pas bien et qu’il a de la fièvre. Les autorités sanitaires ne conseillent pas de tester systématiquement les enfants, sauf si un professionnel de santé le demande.
Conclusion : le virus est toujours là, la vigilance aussi

Selon la source : ukhsa.blog.gov.uk










